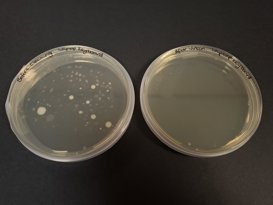

Posted:
11 December 2025
Getting students with SEND & teachers into the lab with CREST Bronze
When Michaela Nelson, a laboratory manager at Bishop Burton College near Kingston upon Hull, heard about CREST she thought it was fantastic. Working on student-led investigative projects and earning CREST Awards would give the students with special educational needs and disabilities (SEND) something to work towards. “That’s what they want”, Michaela told us.
This academic year, Michaela oversaw running Bronze CREST projects in her lab with a whole year group of students with SEND on an Entry Level 3 course, with great success. They tested toothpaste, investigated microbes, and made bath bombs.
This is the third year CREST has been run at Bishop Burton College; the programme has been very popular, but not without initial obstacles.
We spoke to Michaela and her colleague Jack Lamb about preconceptions about students with SEND doing lab work, instilling confidence in teachers and taking the students to London for the Royal Society practical science showcase.

"Teaching staff, not being scientists, didn't have the confidence"
While there are risks involved, practical lab work can allow young people to have fun while meaningfully engaging with science – and this opportunity should be open to students with SEND as well as their peers.
Before Michaela ran CREST in her lab, this had been limited at Bishop Burton College.
SEND students had low level use of the labs as the foundation teaching staff had minimal experience running science practical’s and felt there was limited understanding of adapting practical experiments for SEND students.
She added:
The teaching staff, not being scientists, didn't have the confidence or the knowledge to come in and use the lab.
This has moved forward since Michaela started running Bronze CREST projects; it has proved to be a chance for teachers to see that science doesn’t have to be daunting, as well as an opportunity for students with SEND to do lab work.
Jack, a Course Manager at Bishop Burton, said:
Michaela was incredibly welcoming and supportive, particularly in encouraging students with SEND to engage with the space. Her openness allowed these students to develop valuable practical skills and enrich their overall educational experience.
"Staff-student ratios are really important"
Giving teachers confidence to run practical science experiments is incredibly important for both the teachers and students to have a fulfilling experience, as is having plenty of support in the lab.
Michaela said:
Student-staff ratios are really important, and Bishop Burton have been excellent about offering the Learning Support Assistants’ (LSA) support.
To run the Bronze CREST projects, Michaela worked with her lab technicians, teachers and LSAs to create a safe environment where students could enjoy carrying out their experiments, and staff felt equipped to work with them.
For the teaching staff, because of their limited use of my facility, the whole idea is that we started to get them coming in more. We supported each session.
Michaela told us that she would ensure either she or a technician was present for each lab session, “a proper scientist in there who leads the sessions”.
Now that CREST is in it’s third year at Bishop Burton, Michaela said, “the teaching staff are getting more involved because they know what to do.”
"Having the Grant was integral for starting that first CREST Award"
While all CREST resources are free to access in the Resource Library, there are small CREST fees for students to have their work assessed and to receive certificates. We understand that this can be obstacle to schools with tight budgets, so we offer funding to eligible schools to make CREST more accessible.
For the past two academic years Bishop Burton College has received an Engage Grant, which covers the cost of fees plus funding for other expenses such as equipment or consumable materials to run the projects, and a Simply CREST grant which just covers fees.
Michaela told us after receiving the first Engage Grant,
Having the grant was integral for starting that first CREST Award because it meant we had the resources, which was fantastic, which we can use year on year.
"The students’ STEM skills have been significantly enhanced through their participation in the conference"
To celebrate their launch of a £1.4 million scheme to support practical science in schools, The Royal Society hosted a conference to showcase practical science in November this year.
As a further sign of the great work Michaela and the students did with their CREST projects, were invited along to display their practical work. They took a demonstration of the microbes project; using a lightbox and gel which glowed under UV light to show how germs spread, so the students could share their experiment and findings.
“They talked to everyone who came up to the stand”, Michaela said.
They had something that they could demonstrate and show and did a fantastic job. It was a real boost to their confidence.
Jack has noticed an ongoing improvement in the students’ abilities since their experience at the conference.
“The students’ STEM skills have been significantly enhanced through their participation in the conference,” he told us.
He continued:
Many of the students who attended were initially nervous about speaking to others, especially in unfamiliar or formal settings. However, they gradually grew more self-assured. By the end of the event, they were able to articulate their ideas clearly and confidently while presenting to a large audience—an impressive achievement that reflects their personal and academic growth.
Other news and case studies
 Case studyPosted:14 January 2025
Case studyPosted:14 January 2025Using Engage Grants to run CREST Discovery
 Case studyPosted:20 January 2023
Case studyPosted:20 January 2023Biscuit dunker for a CREST Award!
 Case studyPosted:4 December 2024
Case studyPosted:4 December 2024Linking AI & healthcare - a Gold case study
 Case studyPosted:17 June 2024
Case studyPosted:17 June 2024Widening access to STEM for SEND learners
 Case studyPosted:20 May 2024
Case studyPosted:20 May 2024Exploring reproductive health with CREST